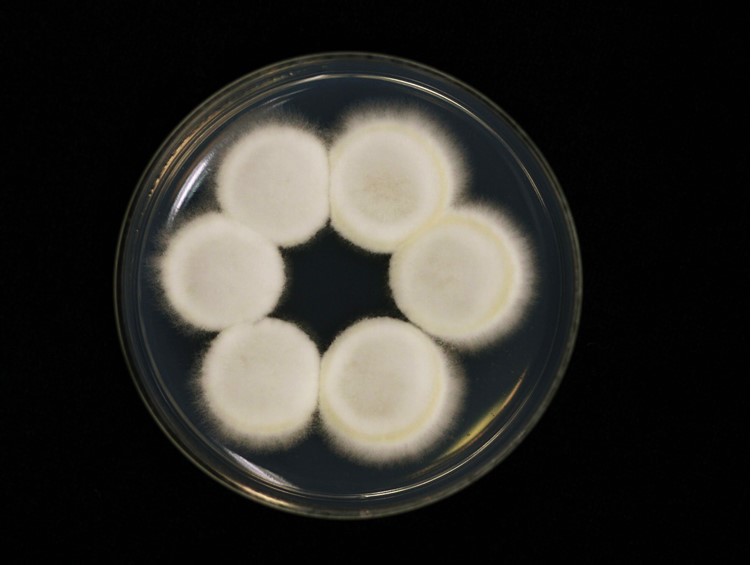

Holotype:
THAILAND, Kalasin Province, Khok Pa Si Community Forest, 14 Aug. 2013, K. Tasanathai, W. Noisripoom, A. Khonsanit, holotype BBH 37600, ex-type living culture BCC 66576.
Habitat:
Buried in the soil.
Host:
On Elaphomyces sp.
Description:
 Stromata, single or multiple, emerging directly from the ground growing on unidentified Elaphomyces sp., clavate, 15-30 mm long, 1-2 mm wide, yellowish green when immature, black when mature. Terminal part of the stroma fertile, capitate, yellow black to black, 2-5 mm diam.
Stromata, single or multiple, emerging directly from the ground growing on unidentified Elaphomyces sp., clavate, 15-30 mm long, 1-2 mm wide, yellowish green when immature, black when mature. Terminal part of the stroma fertile, capitate, yellow black to black, 2-5 mm diam.  Perithecia crowded, ordinal in arrangement, completely immersed, elongate-ovoid, 560-750 × 200- 250 μm.
Perithecia crowded, ordinal in arrangement, completely immersed, elongate-ovoid, 560-750 × 200- 250 μm.  Asci cylindrical, 8-spored, 318-482 × 7-8 μm with thickened ascus caps, 4.5-5 × 5 μm.
Asci cylindrical, 8-spored, 318-482 × 7-8 μm with thickened ascus caps, 4.5-5 × 5 μm.  Ascospores hyaline, filiform, 310-395 × 1.5-2 μm, breaking into 64 cylindrical part-spores, 2-5 × 1.5-2 μm.
Ascospores hyaline, filiform, 310-395 × 1.5-2 μm, breaking into 64 cylindrical part-spores, 2-5 × 1.5-2 μm.
Culture characteristics:
Colonies on PDA moderately growing, funiculose, ca 10 mm diam after 3 w at 25 °C, white to smoke grey with age. Colonies reverse cream. Conidiophores erect, arising from vegetative hyphae. Conidia single-celled, hyaline, smooth, globose, 3–5 μm diam, produced in slimy heads.
Colonies on PDA moderately growing, funiculose, ca 10 mm diam after 3 w at 25 °C, white to smoke grey with age. Colonies reverse cream. Conidiophores erect, arising from vegetative hyphae. Conidia single-celled, hyaline, smooth, globose, 3–5 μm diam, produced in slimy heads.
Reference:
Crous PW, Cowan DA, Maggs-Kölling G, et al. (2020). Fungal Planet description sheets. Persoonia 45: 251–409.
DOI: https://doi.org/10.3767/persoonia.2020.45.10Species |
Strain |
Compound |
Pubchem CID |
Biological activity |
Reference |
|---|
|
Strain |
ITS | LSU | RPB1 | TEF1 |
|---|---|---|---|---|
| BCC 66576 | MN338090 | MN337287 | MN338495 | |
| BCC 66578 | MN338091 | MN337288 | MN338496 | |
| BCC 66580 | - | MN337289 | MN338497 | MN338497 |